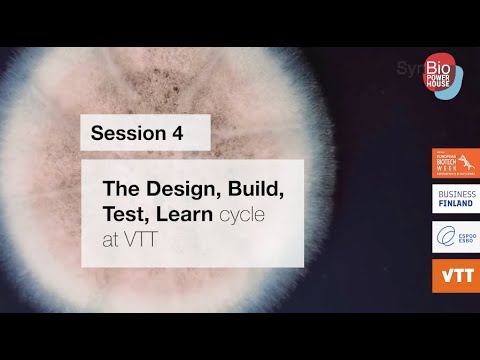
The Design Build Test Learn Capabilities and infrastructure at VTT ...

Build/test Learn Idea Data Validate
Celebrate the seasons with our stunning Build/test Learn Idea Data Validate collection of hundreds of seasonal images. highlighting time-sensitive photography, images, and pictures. designed to celebrate natural cycles and changes. Browse our premium Build/test Learn Idea Data Validate gallery featuring professionally curated photographs. Suitable for various applications including web design, social media, personal projects, and digital content creation All Build/test Learn Idea Data Validate images are available in high resolution with professional-grade quality, optimized for both digital and print applications, and include comprehensive metadata for easy organization and usage. Explore the versatility of our Build/test Learn Idea Data Validate collection for various creative and professional projects. Each image in our Build/test Learn Idea Data Validate gallery undergoes rigorous quality assessment before inclusion. Whether for commercial projects or personal use, our Build/test Learn Idea Data Validate collection delivers consistent excellence. Instant download capabilities enable immediate access to chosen Build/test Learn Idea Data Validate images. Regular updates keep the Build/test Learn Idea Data Validate collection current with contemporary trends and styles. Advanced search capabilities make finding the perfect Build/test Learn Idea Data Validate image effortless and efficient. Reliable customer support ensures smooth experience throughout the Build/test Learn Idea Data Validate selection process.

![Train Test Validation Split: How To & Best Practices [2023]](https://assets-global.website-files.com/5d7b77b063a9066d83e1209c/61568656a13218cdde7f6166_training-data-validation-test.png)









































.webp)







_(1).jpg)